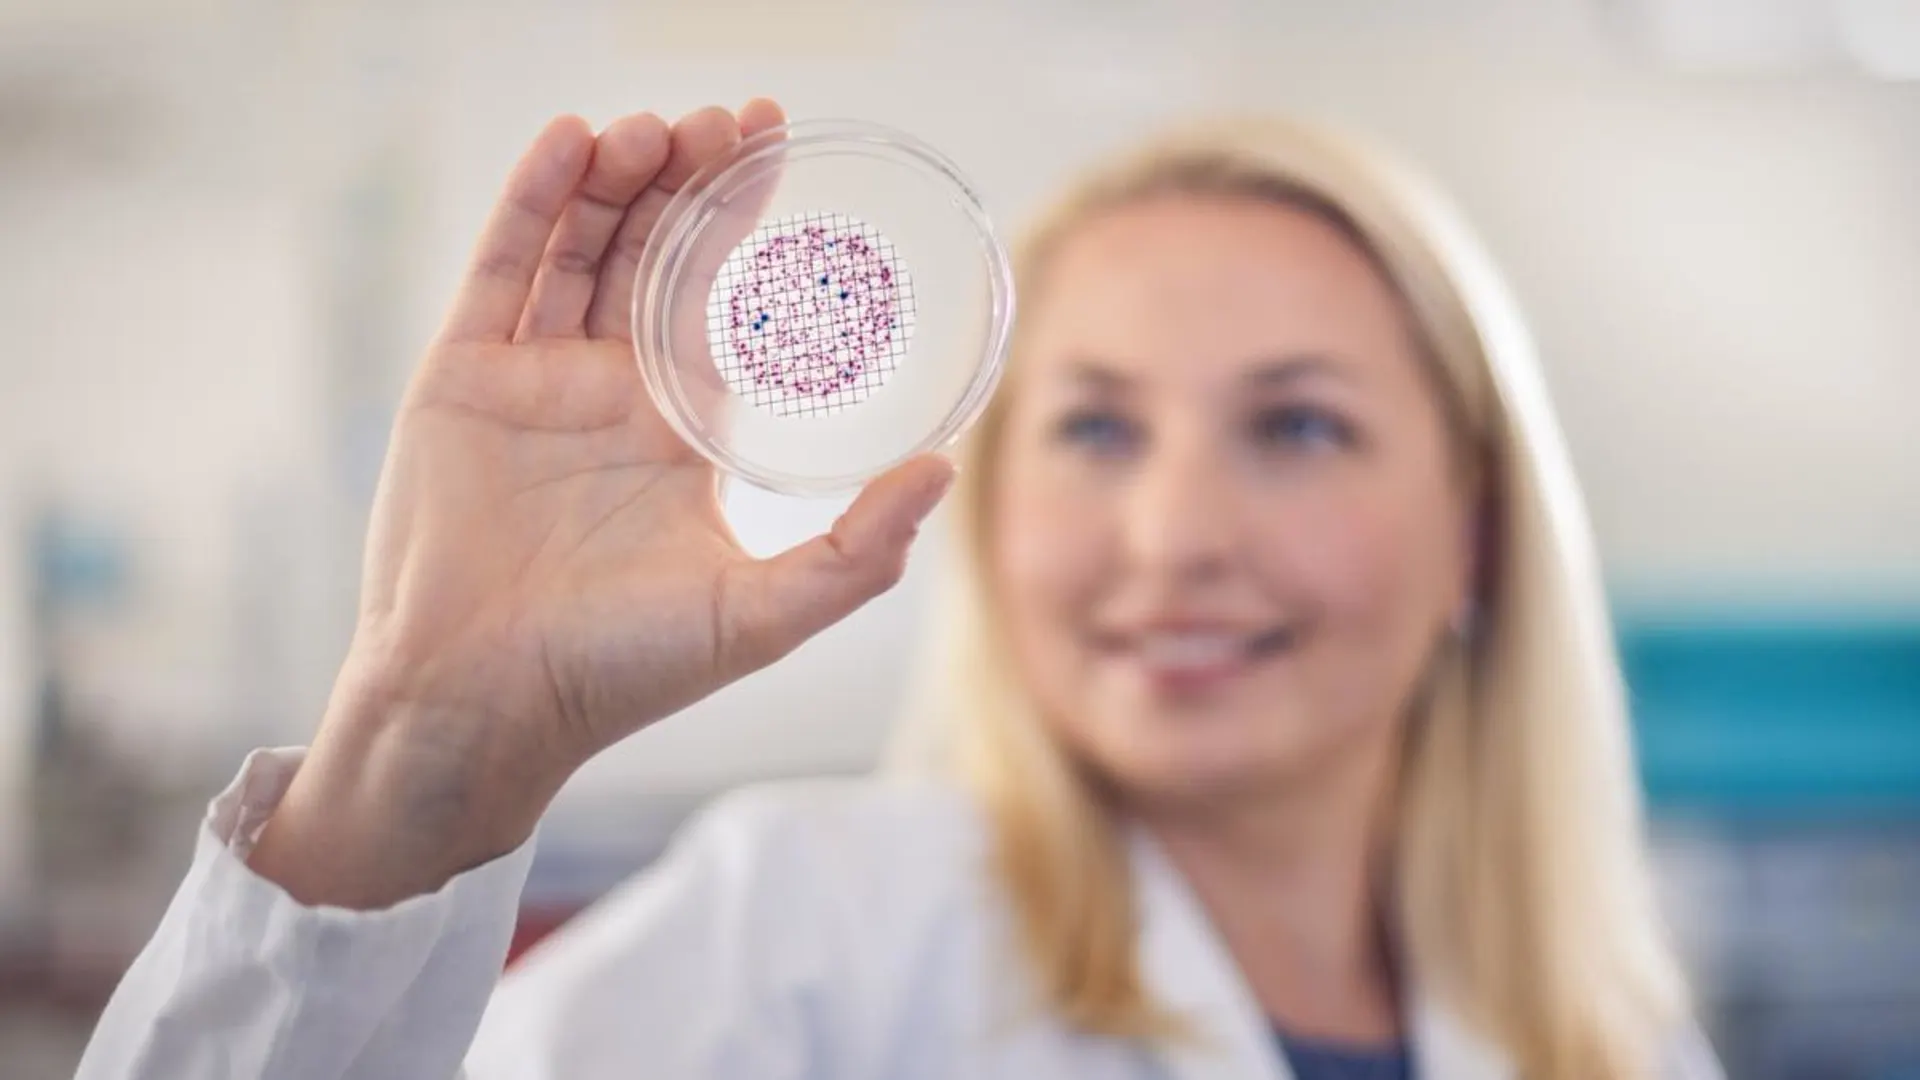
Wasserlabor Niederrhein Die WLN führt Untersuchungen von Trinkwasser, Rohwasser und Badewasser durch.

Trinkwasser
Informationszentrum Trinkwasser in Helenabrunn
Wassergewinnung und Aufbereitungstechnik
Im Wasserwerk Helenabrunn befindet sich das 1991 gegründete Informationszentrum Trinkwasser, wo auf anschauliche Weise Gewinnung von Trinkwasser und dessen Aufbereitung dargestellt werden. Gehen Sie im Informationszentrum auf Entdeckungstour und informieren Sie sich über die Geschichte unseres Trinkwassers.